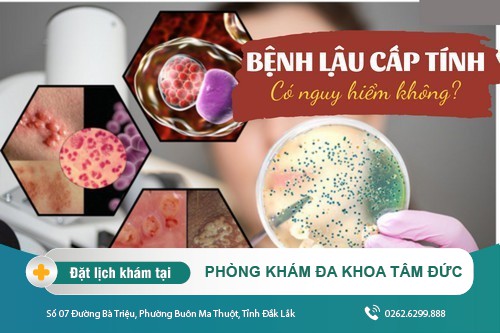

Rất nhiều bệnh nhân cho rằng đi Sài Gòn điều trị bệnh thì có thể đạt được hiệu quả cao. Nhưng lại không biết hiện tại ở thành phố Buôn Ma Thuột tỉnh Đắk Lắk cũng có cơ sở chuyên khoa y tế điều trị hiệu quả các bệnh lý chẳng kém gì Sài Gòn. Đối với mỗi bệnh nhân thì việc chọn 1 cơ sở chuyên khoa uy tín, hiệu quả cao mà vẫn đảm bảo chi phí hợp lý và tiết kiệm thời gian là vô cùng quan trọng.
Bệnh lậu cấp tính là những giai đoạn đầu của bệnh lậu, ở gian đoạn cấp tính việc điều trị sẽ dễ dàng hơn so với giai đoạn mãn tính. Bài viết dưới đây sẽ tổng hợp những cách điều trị bệnh lậu cấp tính hiệu quả ít tái phát
Bệnh lậu là một bệnh xã hội lây lan qua đường quan hệ tình dục không an toàn do vi khuẩn Neisseria gonorrhoeae gây ra. Vi khuẩn lậu gây nhiễm trùng đường sinh dục, cũng có thể xuất hiện ở miệng, mắt, hậu môn… của người bệnh.
Lậu là một trong những loại bệnh lây nhiễm đường tình dục phổ biến. Thông thường lậu cấp tính có biểu hiện phát sinh rất đột ngột, làm người bệnh đối phó không kịp trở tay.
Bệnh lậu được phân thành 2 giai đoạn là lậu cấp tính và lậu mãn tính. Sau khoảng 3 - 7 ngày ủ bệnh, bệnh lậu sẽ bước vào giai đoạn cấp tính với những biểu hiện cụ thể như:
✜ Tiểu buốt, tiểu rắt, đau buốt khi đi tiểu, buồn tiểu liên tục. Nước tiểu có màu đục, mùi khai nồng nặc, đôi khi đi tiểu ra máu.
✜ Sưng tấy ở lỗ sáo, niệu đạo, dương vật, âm hộ ngứa ngáy, khó chịu.
✜ Đau khi quan hệ tình dục hay khi xuất tinh. Đau bụng dưới và lan ra sống lưng. Đôi khi sốt cao, ớn lạnh…
✜ Bệnh lậu gây chảy mủ từ niệu đạo của nam giới, còn nữ giới sẽ bị ra nhiều khí hư có mùi hôi tanh.
✜ Cũng có thể xuất hiện triệu chứng đau họng, có vết loét, sưng tấy ở khoang miệng, mắt, hoặc chảy mủ ở hậu môn nếu những bộ phận này bị nhiễm vi khuẩn lậu.
Những biểu hiện của bệnh lậu
➥ Các bác sĩ nhấn mạnh rằng thời gian chuyển từ bệnh lậu cấp tính sang mãn tính rất ngắn, chỉ khoảng 2 đến 7 ngày sau khi phát bệnh. Trong khi đó, việc hỗ trợ điều trị bệnh lậu sớm ở giai đoạn cấp tính rất dễ dàng. Nhưng khi bệnh đã chuyển sang mãn tính thì việc điều trị sẽ khó khăn hơn rất nhiều, phải điều trị kiên trì trong thời gian rất dài với chi phí cực lớn, và khả năng tái phát cao hơn do vi khuẩn đã lây lan rộng và gây nhiều tổn thương cho cơ thể.
Bệnh lậu cấp tính cũng gây ra không ít tác hại nghiêm trọng, đe dọa trực tiếp sức khỏe và sinh hoạt hàng ngày của người bệnh.
➤ Gây cho người bệnh cảm giác sợ hãi, lo lắng, tự ti.
➤ Sức khỏe của người bệnh bị suy yếu rõ rệt do tình trạng ngứa ngáy, đau rát, nóng sốt thường xuyên diễn ra.
➤ Cuộc sống sinh hoạt hàng ngày của bệnh nhân bị đảo lộn, thường xuyên đau rát bộ phận sinh dục, đặc biệt là khi tiểu tiện và lúc quan hệ tình dục.
➤ Cuộc sống vợ chồng dần trở nên xa cách, dễ dẫn đến tan vỡ hạnh phúc gia đình.
➥ Bệnh lậu cấp tính nếu không được phát hiện và điều trị sớm sẽ chuyển sang giai đoạn mãn tính kèm theo nhiều hệ lụy vô cùng nguy hiểm, thậm chí có thể dẫn tới tử vong. Vì vậy, khi bản thân có các triệu chứng của bệnh lậu nêu trên, bạn nên tới ngay các cơ sở y tế, phòng khám chuyên khoa uy tín để thăm khám và điều trị bệnh kịp thời.
Nhiều người lầm tưởng lậu không thể chữa được. Vì thế khi mắc bệnh, họ thường tỏ ra chán nản và bi quan. Tuy nhiên, theo các chuyên gia y tế Phòng Khám Đa khoa Tâm Đức, bệnh này có thể được điều trị khỏi nếu được phát hiện sớm và chữa trị đúng cách.
++ Chữa trị nội khoa: Dùng thuốc kháng sinh chuyên dụng đặc trị sẽ giúp ức chế, đào thải vi khuẩn, khống chế sự xâm nhập, tấn công của lậu khuẩn và khử trùng các vết thương đang lở loét cũng là một cách để trị bệnh. Căn cứ vào kết quả kiếm tra bác sĩ sẽ kê toan thuốc có liều lượng phù hợp với thể trạng của bệnh nhân.
++ Chữa trị ngoại khoa: Áp dụng công nghệ DHA chính là giải pháp hoàn hảo cho những người không may bị bệnh lậu. Đây là phương pháp áp dụng với trường hợp bệnh lậu mãn tính, dưới tác động của nhiệt điện trường và sóng cao tần tiến sát vào các tế bào lậu khuẩn sẽ được tiêu diệt sạch từ sâu bên trong một cách nhẹ nhàng, nhanh chóng, không đau và ngăn ngừa khả năng tái phát.

Phòng Khám Đa khoa Tâm Đức - Địa chỉ điều trị bệnh lậu uy tín tại Đắk Lắk
Để việc điều trị bệnh lậu cấp tính đạt hiệu quả cao, người bệnh cần lưu ý:
➥ Không nên quan hệ tình dục (cho đến khi lành bệnh, tránh lây nhiễm cho người khác)
➥ Chế độ ăn uống khoa học
➥ Làm việc và nghỉ ngơi hợp lý
➥ Giữ gìn vệ sinh sạch sẽ
Lậu tuy là một bệnh nguy hiểm nhưng cũng có cách để phòng ngừa bệnh có hiệu quả: quan hệ tình dục lành mạnh, an toàn, chung thủy, vệ sinh sạch sẽ cho cả nam và nữ trước khi quan hệ tình dục là cách tốt giúp chúng ta phòng tránh các bệnh lây truyền qua đường tình dục trong đó có bệnh lậu. Điều quan trọng là khi có bệnh thì nên sớm đi khám để được điều trị.
➥ Mọi thông tin chi tiết đăng ký khám chữa bệnh hoặc tư vấn giải đáp thắc mắc về các vấn đề trên vui lòng gọi đến Hotline 0262.6299.888, hoặc nhanh hơn bằng cách nhấp vào BẢNG TƯ VẤN để có thể trao đổi trực tiếp với các bác sĩ chuyên khoa
Lưu ý: Bài viết trên đây chỉ mang tính chất tham khảo, vì thế bạn nên đến thăm khám trực tiếp tại phòng khám hoặc bỏ ra vài phút để tư vấn trực tuyến với chuyên gia, qua đó lựa chọn cho mình phương pháp điều trị hiệu quả nhất. Khi đặt lịch khám online bạn sẽ được miễn phí khám lâm sàng, ưu tiên khám trước và được nhận nhiều ưu dãi vô cùng hấp dẫn khác.
TIN TỨC XEM NHIỀU
đăng ký khám onlineThời gian làm việc
Địa chỉ: Số 07 Đường Bà Triệu, Phường Buôn Ma Thuột, Tỉnh Đắk Lắk
Điện thoại:
0262.6299.888
Thời gian làm việc: từ 08h00 - 18h00